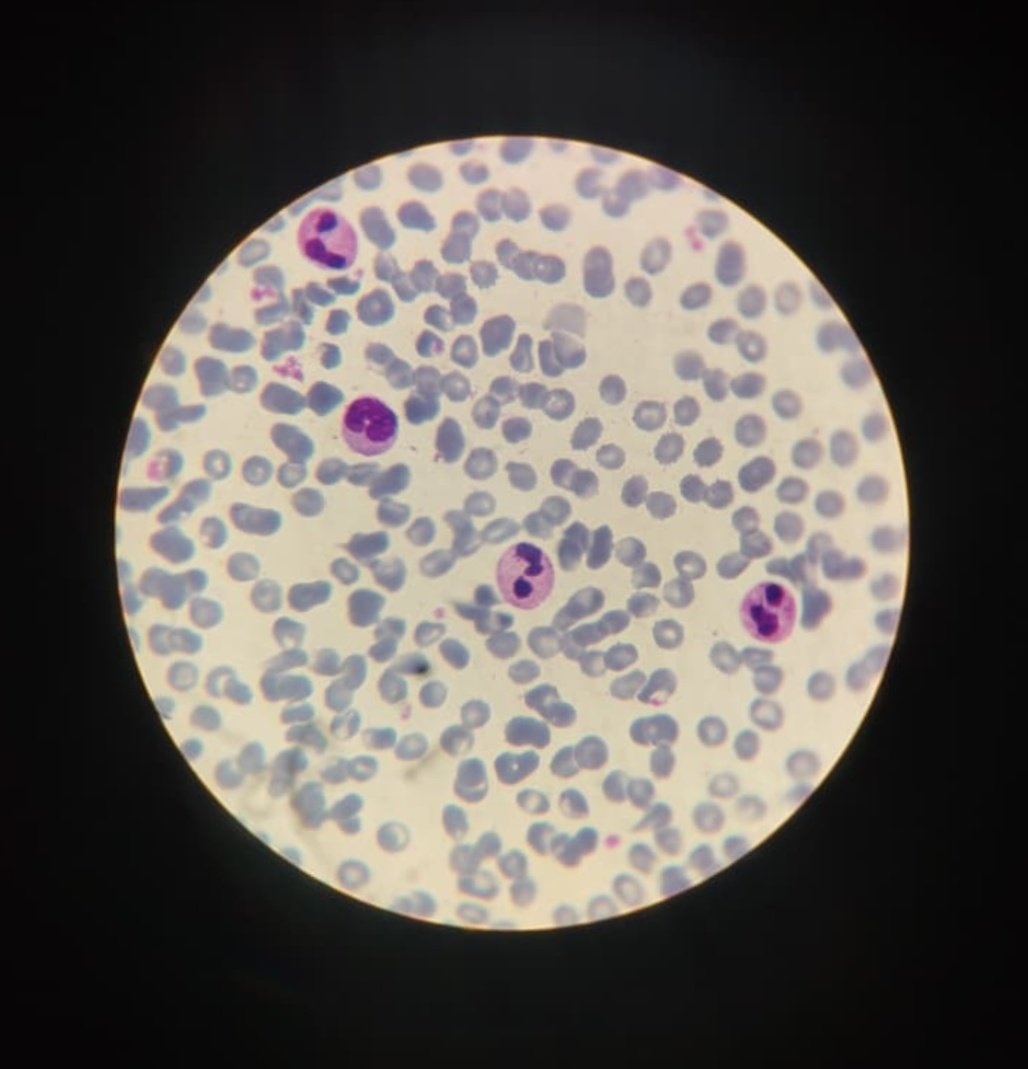
La imagen muestra leucocitos al microscopio, células clave del sistema inmunológico. Se distinguen por su núcleo y su función en la defensa del organismo.Son esenciales para combatir infecciones y mantener el equilibrio interno del cuerpo
#HistologíaHematologíaInmunología
#UCMLT

Lidia María
@lidiamara169749
ID: 1976340691061035008
09-10-2025 17:39:37
1,1K Tweet
22 Takipçi
14 Takip Edilen



👉Ahora llega al puerto de #LaHabana buques de la armada de #México con el primer envío de ayuda humanitaria del gobierno de Claudia Sheinbaum Pardo #CubaNoEstáSola #CubaEstaFirme



Esta semana el Presidente Miguel Díaz-Canel Bermúdez chequeó Programa de desarrollo de vacunas antineumocócicas conjugadas, de Instituto Finlay de Vacunas. Se avanza en nuevos candidatos que de gran impacto en la calidad de vida de nuestro pueblo, especialmente de nuestro niños más pequeños.






🧑🏻⚕️🇨🇺 La Dra. Mariuska Forteza, jefa de Oncopediatría del Instituto de Oncología y Radiobiología 🇨🇺 denuncia: el bloqueo de EE.UU. obliga a modificar protocolos y reajustar dosis en tratamientos contra el cáncer infantil. A pesar de ello, tenemos tasas de supervivencia comparables a las de países desarrollados.


"Cuba es una nación libre, independiente y soberana. Nadie nos dicta qué hacer. Cuba no agrede, es agredida por EE.UU. hace 66 años, y no amenaza, se prepara, dispuesta a defender a la patria hasta la última gota de sangre". Miguel Díaz-Canel Bermúdez #CubaEstáFirme #LasTunasPorLaSalud



Ante el Bloqueo servicio de Nefrología de #LasTunas garantiza la mayor tasa de supervivencia y de recuperación de los pacientes #CubaPorLaSalud #TumbaElBloqueo alibarrios Dirección General de Salud Las Tunas Luisa Elena Rivera Yamileydis Montoya Yenima Díaz






Día Mundial de la Radio, efeméride proclamada por la Asamblea General de las Naciones Unidas en el año 2012. #PorLasTunasLaVictoria #PorUn26EnEl26 #AcreditandoElPresente #CubaPorLaVida Osbel Lorenzo Yelenys Tornet Menéndez Enelis Reyes